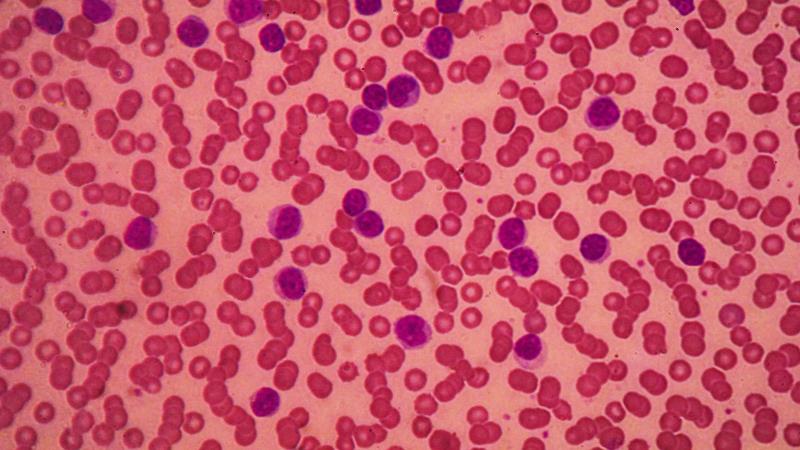

Patients with relapsed/refractory (R/R) chronic lymphocytic leukaemia or small lymphocytic lymphoma (CLL/SLL) may have a greater response to zanubrutinib than ibrutinib as well as better progression-free survival (PFS), according to the first interim analysis results of the ALPINE trial.
“In this interim analysis of the randomized phase III ALPINE study in patients with R/R CLL/SLL, zanubrutinib was shown to have a superior response rate, an improved PFS rate, and a lower rate of atrial fibrillation or flutter, compared with ibrutinib,” presented study author Professor Peter Hillmen from the St James University Hospital, Leeds, UK, at EHA 2021.
The results were based on analysis of the first 415 (of the planned 652) patients (median age 67 years) with R/R CLL/SLL who had been randomized 1:1 to receive zanubrutinib (160 mg BID; 68.6 percent male) or ibrutinib (420 mg QD; 75.0 percent male) until disease progression. Patients with prior exposure to Bruton’s tyrosine kinase (BTK) inhibitors were excluded, as were those on warfarin or other vitamin K antagonists. About 62 percent were aged ≥65 years. Just under 20 percent of patients had del(17p) and/or TP53 mutation, and 25–30 percent had del11q mutations.
At a median 15 months of follow-up, overall response rate (ORR), as per investigator assessment, was significantly improved with zanubrutinib vs ibrutinib (78.3 percent vs 62.5 percent; 2-sided p=0.0006*). [EHA 2021, abstract LB1900]
Of these, 1.9 and 1.4 percent of zanubrutinib and ibrutinib recipients, respectively, had complete response, 75.8 and 61.1 percent had partial response, 10.1 and 18.8 percent had partial response with lymphocytosis, and 8.2 and 13.5 percent had stable disease. Six and nine patients, respectively, discontinued treatment or initiated a new therapy prior to assessment.
When looking at specific mutations, zanubrutinib improved ORR compared with ibrutinib in patients with del17p mutations (83.3 percent vs 53.8 percent). The ORR outcomes generally favoured zanubrutinib in analysis of various subgroups including age, sex, disease stage, and del(17p) and/or TP53 mutation.
Interim investigator-assessed PFS was also better with zanubrutinib vs ibrutinib (12-month PFS: 94.9 percent vs 84.0 percent; hazard ratio [HR], 0.40, 95 percent confidence interval [CI], 0.23–0.69; p=0.0007). Interim overall survival (OS) was also improved with zanubrutinib vs ibrutinib, though this was not significant (12-month OS: 97.0 percent vs 92.7 percent; HR, 0.54, 95 percent CI, 0.25–1.16; p=0.1081).
The pre-specified safety endpoint of atrial fibrillation or flutter occurred at a lower rate among zanubrutinib than ibrutinib recipients (2.5 percent vs 10.1 percent; 2-sided p=0.0014*).
Grade ≥3 adverse events (AEs) occurred in 55.9 and 51.2 percent of zanubrutinib and ibrutinib recipients, respectively, while serious AEs occurred in 27.5 and 32.4 percent, respectively.
Major bleeding was less common among zanubrutinib than ibrutinib recipients (2.9 percent vs 3.9 percent), as were AEs leading to discontinuation (7.8 percent vs 13.0 percent), grade ≥3 infections (12.7 percent vs 17.9 percent), and death (3.9 percent vs 5.8 percent). In contrast, neutropenia was more common with zanubrutinib than ibrutinib (28.4 percent vs 21.7 percent).
Approximately 87 and 75 percent of zanubrutinib and ibrutinib recipients, respectively, remain on treatment.
“The treatment of CLL/SLL has been transformed with the advent of effective inhibitors of B-cell receptor signalling, such as the BTK inhibitor ibrutinib,” said Hillmen.
“Zanubrutinib, an irreversible, potent, next-generation BTK inhibitor, is designed to maximize BTK occupancy and minimize off-target inhibition of TEC- and EGFR-family kinases,” he continued. The hypothesis was that zanubrutinib would both minimize ibrutinib off-target inhibition-related toxicities while also improving outcomes.
“These data support that more selective BTK inhibition, with more complete and sustained BTK occupancy, results in improved efficacy and safety outcomes than a less specific BTK inhibitor,” Hillmen said.
*pre-specified alpha for interim analysis: p=0.0099